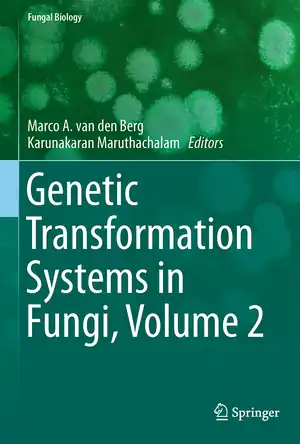
Buchcover ISBN 9783319105024

Buchdetails zu ISBN 9783319105024
Informationen und Bezugsquellen zu diesem Buch finden Sie auf ISBN.de.
Direktlink: https://www.isbn.de/9783319105024
Dieser QR-Code leitet direkt zur Buchseite auf ISBN.de weiter.
58n.de bietet ausschließlich die technische Weiterleitung – Inhalt & Metadaten finden Sie auf ISBN.de.